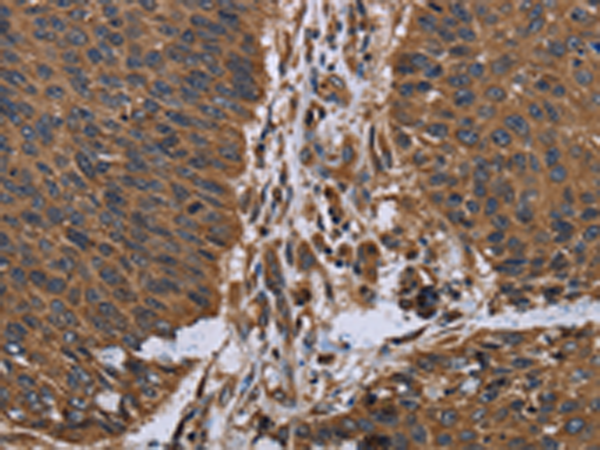
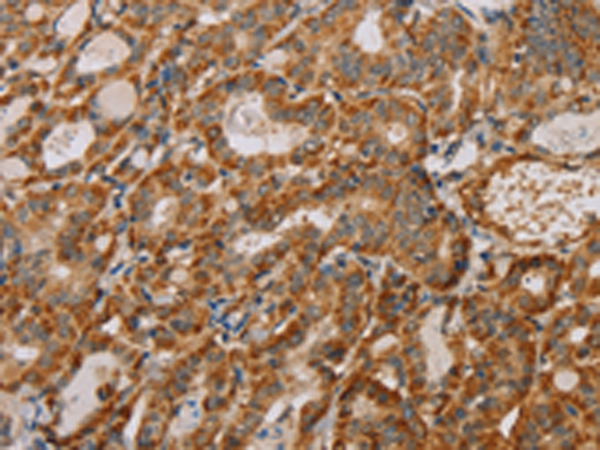
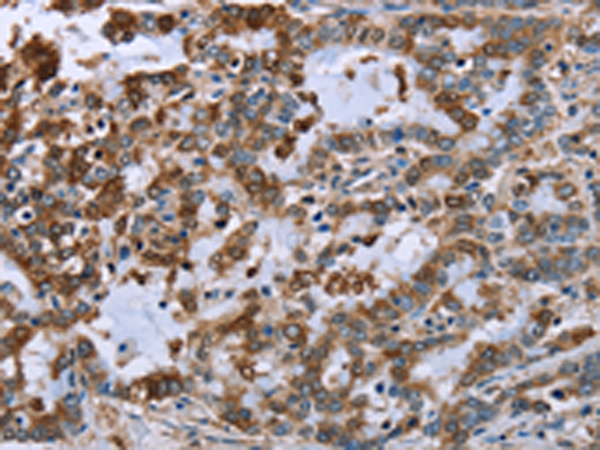

-
分类: 科研抗体货号: P01512别名: GRCB; LEPREL2; HSU47926应用: WB,IHC反应种属: Human, Mouse
-
分类: 科研抗体货号: P01483别名: LAD; CD18; MF17; MFI7; LCAMB; LFA-1; MAC-1应用: IHC反应种属: Human, Mouse
-
分类: 科研抗体货号: P01572别名: ALP; NET43应用: WB,IHC反应种属: Human, Mouse
-
分类: 科研抗体货号: P01511别名: DLD应用: IHC反应种属: Human
-
分类: 科研抗体货号: P01481别名: GT; GTA; CD41; GP2B; HPA3; CD41B; GPIIb; BDPLT2; BDPLT16应用: WB,IHC反应种属: Human, Mouse
-
分类: 科研抗体货号: P01562别名: CHPPR; FAM54A2应用: WB,IHC反应种属: Human
-
分类: 科研抗体货号: P01509别名: LCMT; PPMT1; CGI-68应用: IHC反应种属: Human, Rat
-
分类: 科研抗体货号: P01478别名: IMPD2; IMPDH-II应用: WB,IHC反应种属: Human, Mouse, Rat
-
分类: 科研抗体货号: P01553别名: ATLD; HNGS1; MRE11A; MRE11B应用: WB,IHC反应种属: Human, Mouse, Rat
-
分类: 科研抗体货号: P01508别名: GBP; ECHA; HADH; LCEH; MTPA; LCHAD; TP-ALPHA应用: WB,IHC反应种属: Human, Mouse, Rat

鄂公网安备42018502007531号
鄂公网安备42018502007531号

